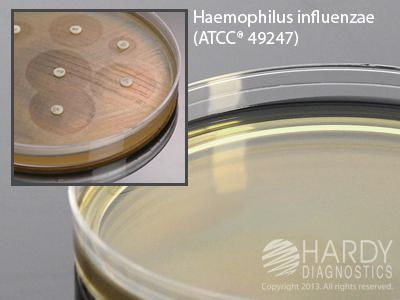
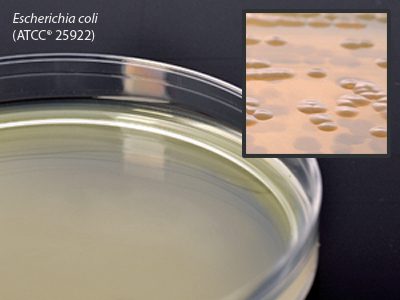

Bioreagents
Indoxyl Acetate Disks, rapid test for Campylobacter, Hardy Diagnostics – Z111, Indoxyl Acetate Disks
$54.07INDOXYL ACETATE RAPID TEST 25 DISKS
Nitrate Substrate Broth, Hardy Diagnostics – R97, 13 x 100 mm, Nitrate Substrate Broth
$64.46MEDIUM NITRATE SUBSTRATE BROTH 2 ML TUBE
Trichophyton Agar, Hardy Diagnostics – C54, 20 x 125 mm, Trichophyton #4
$103.83TRICHOPHYTON NO 4 20X125MM TUBE 10.5 ML
Middlebrook 7H9 Broth, Hardy Diagnostics – C32, 16 x 125 mm, Middlebrook 7H9 Broth
$89.36MEDIUM MIDDLEBROOK 7H9 BROTH 10 ML TUBE
McKesson Antimicrobial Soap Lotion with Aloe, Hardy Diagnostics – 937911, McKesson Antimicrobial Soap Lotion with Aloe
$67.02LOTION MCKESSON A-MICBL SOAP W/ALOE 1GAL
Tryptic Soy Broth (TSB) w/15% Glycerol, Hardy Diagnostics – R34, 13 x 100 mm, Tryptic Soy Broth (TSB) with 15% Glycerol
$41.42MEDIUM TSB W/15% GLYCEROL 2 ML IN TUBE
GRAMS IODINE STABILIZED 4OZ AMBER BOTTLE – QS2000, 100 ml (4 oz.)
$21.62GRAMS IODINE STABILIZED 4OZ AMBER BOTTLE
Potato Flake Agar, Hardy Diagnostics – W59, 15×100 mm, Potato Flake Agar
$25.84POTATO FLAKE AGAR DEEP FILL 15X100MM PLT
Nutrient Agar, Hardy Diagnostics – W31, 15 x 100 mm, Nutrient Agar Plate
$10.94NUTRIENT AGAR MEDM 15X100 MM PLT W/O LBL
HTM Agar (Haemophilus Test Medium) for susceptibility testing, Hardy Diagnostics – H07, 15 x 150 mm, HTM Agar, Haemophilus Test Medium
$40.43MEDIUM HTM AGAR 15 X 150 MM PLATE LARGE
BHI (Brain Heart Infusion) Agar, Hardy Diagnostics – A20, 15 x 100 mm, BHI Agar with 5% Sheep Blood
$28.81MEDIUM BHI AGAR 5% SHEP BLD 15X100MM PLT
Casein Agar, Hardy Diagnostics – G122, 15 x 100 mm, Casein Agar
$66.92MEDIUM CASEIN AGAR 15X100MM PLATE 18 ML